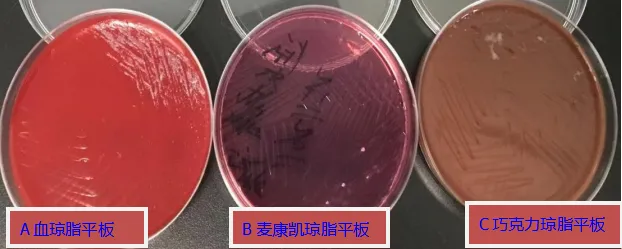
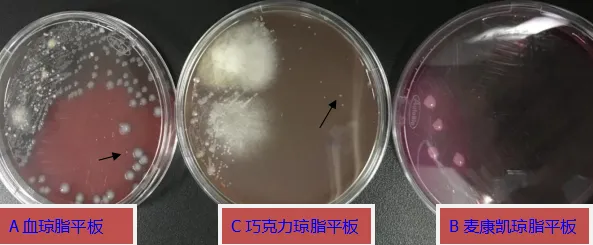

患者肺泡灌洗液(Bronchoalveolar Lavage Fluid 简称BALF)培养有脓肿诺卡氏菌(Nocardia abscessus)生长。脓肿诺卡氏菌极易引起人的播散性感染(无论患者免疫功能是否受损),且易侵袭到中枢神经系统。
目前已有从支气管灌洗液、脑脓肿、血液、眼部分泌物中分离和引起系统性感染的报道[1]。脓肿诺卡氏菌导致肺部感染的病例少见。
诺卡菌氏属(Nocardia)属于细菌域→放线菌门→放线菌纲→放线菌目→诺卡氏菌科,广泛分布于土壤中。感染途径主要通过呼吸道进入机体导致肺部感染;也可引起皮肤软组织感染和中枢神经系统感染。
患者陶某某,男性,67岁;入院时间:2025年11月20日。主诉:反复咳喘6年,加重1周。
既往史:否认传染病史、手术史、外伤史。无输血史、过敏史。
现病史:患者自诉近6年余来,每遇天气转冷,即有咳嗽、咯痰,清晨咳嗽较剧,痰量少,白色粘稠,并感呼吸困难。表现为吸气及呼气费力,无咯血及盗汗。每年发作2~3次,多在秋末冬初时。近1周来患者因受凉上述症状再发,咳嗽呈阵发性,痰多,为黄白色粘痰,喘息明显,稍有活动便觉喘息,伴气促、胸闷,右侧腰腹部带状疱疹疼痛、部分结痂。11月20日到医院就诊,以“慢性阻塞性肺病伴有急性加重”入院。
查体:喘息貌,口唇发绀,胸廓桶状,肋间隙增宽,辅助呼吸肌参与呼吸运动。胸壁无静脉怒张及压痛。双肺叩诊呈过清音,两肺呼吸音较弱,呼气音延长,未闻及干湿啰音,未闻及哮鸣音。入院随机血糖:12.6mmol/L。
初步诊断:慢性阻塞性肺病伴有急性加重(E组 慢性阻塞性肺气肿)、社区获得性肺炎、Ⅱ型呼吸衰竭、慢性肺源性心脏病、右心衰竭、陈旧性肺结核。
实验室检查:
微生物检查。11月26日,BALF脓样、粘稠、咖啡色。涂片革兰氏染色(批号C250803/效期20270828)镜检:“检出革兰氏阳性分枝杆菌(形似诺卡氏菌,如箭头所示)。”
革兰氏染色阳性杆菌,分枝状、丝状、串珠状,结合抗酸染色阴性和弱抗酸染色阳性初步鉴定诺卡氏菌属。对患者诺卡菌氏菌病诊断及治疗有重要价值。抗酸染色(批号C250601/效期20270609)镜检:阴性,未见抗酸杆菌。
可排除结核分枝杆菌和快速生长分枝杆菌。弱抗酸染色(批号202505121/效期20260821)镜检:阳性,检出弱抗酸菌(形似诺卡氏菌),提示诺卡菌氏菌属。标本及涂片结果详见图1-图4。

图1 BALF外观脓样、粘稠、咖啡色。


见革兰氏阳性分枝杆菌,如箭头所示。 可排除结核分枝杆菌和快速生长分枝菌。

图4 BALF弱抗酸染色镜检:×1000,阳性,如箭头所示
11月26日BALF培养。接种血琼脂平板、麦康凯琼脂平板、巧克力琼脂平板,置35℃5%CO2环境培养,同时在平板上注明“延长培养,勿丢”。
培养24小时血琼脂平板有白色光滑圆形凸起小菌落生长。巧克力琼脂平板和麦康凯琼脂平板无白色光滑圆形凸起小菌落生长。该菌落革兰氏染色镜检:假丝酵母菌; 细菌鉴定:近平滑假丝酵母菌。该菌属于口腔正常定植菌群。
根据原始标本涂片革兰氏染色结果(未见假丝酵母菌及丝状真菌菌丝)和行业标准,对于免疫力正常人群,即使从下呼吸道标本中分离到假丝酵母菌,无需鉴定、药敏试验和报告。
例外情况,有组织病理学证据,肿瘤患者如:白血病,肺移植患者和新生儿,则需鉴定来自下呼吸道标本中的假丝酵母菌[2]。
延长培养至12月2日,血琼脂平板、巧克力琼脂平板均有灰色、白色、干燥、质地硬(菌落用接种环难以挑起)、针尖样菌落生长。巧克力琼脂见两颗蓬松棉絮样菌落,为曲霉,(曲霉为污染菌,原始涂片未见假丝酵母菌孢子及丝状真菌菌丝)。培养结果见图5-图6。
图5 11月27日培养24小时:A血琼脂平板有假丝酵母菌生长,B麦康凯琼脂平板和C巧克力琼脂平板无假丝酵母菌生长
图6 12月2日培养6天,A血琼脂平板、C巧克力琼脂平板见白色干燥小菌落;B麦康凯琼脂平板无干燥小菌落
12月2日,巧克力琼脂小菌落质谱(Autof Ms1000)细菌鉴定。菌落涂布靶板待干,加质谱样本预处理试剂(批号20250522/效期20260521)裂解液11μL待干,加裂解液2 1μL待干,加基质液1μL待干,上机鉴定:诺卡氏菌属脓肿诺卡氏菌,鉴定值8.423(6.0-9.0属水平可信)。
因种可信值低,菌种分纯血琼脂平板。12月6日血琼脂平板见白色、干燥、光滑、凸起小菌落。进行革兰氏染色、弱抗酸染色和抗酸染色镜检,染色结果与原始标本染色结果一致。
菌种纯培养安图质谱鉴定:诺卡氏菌属脓肿诺卡氏菌,鉴定值9.393(9.0-9.5种水平可信;9.5-10.0亚种水平可信)。鉴定结果见图7-图8。
 图7 12月2日质谱鉴定:诺卡氏菌属脓肿诺卡氏菌,鉴定值8.423,属水平可信
图7 12月2日质谱鉴定:诺卡氏菌属脓肿诺卡氏菌,鉴定值8.423,属水平可信

图8 12月6日质谱鉴定:脓肿诺卡氏菌,鉴定值9.393,种水平可信
实验室感染标志物检查:2025年11月20日至11月29日检测降钙素原(PCT)和白细胞(WBC )、中性粒细胞绝对值(NEU#)、中性粒细胞百分比(NEU%)。检测结果随治疗时间变化,结果的变化趋势为逐渐下降。详见图9。

图9 感染标志物变化趋势图
脓肿诺卡氏菌属于放线菌目,专性需氧,生长缓慢。革兰染色阳性,菌体呈多向分枝丝状。弱抗酸染色呈阳性,抗酸染色阴性,据此与放线菌属、结核分枝杆菌和快速生长分枝杆菌区别。放线菌专性厌氧菌,弱抗酸染色、抗酸染色均阴性;结核分枝杆菌和快速生长分枝杆菌弱抗酸染色、抗酸染色均阳性。
诺卡氏菌属中,脓肿诺卡氏菌导致肺部感染不常见。星形诺卡氏菌感染在我国最常见,致病力最强,是诺卡氏菌病的主要病原体。在检验工作中,标本涂片革兰氏染色和抗酸染色、弱抗酸染色对提高脓肿诺卡氏菌的检出率有重要价值。
本例脓肿诺卡氏菌患者有明显的下呼吸道感染症状,根据相关指南制定治疗方案:《热病》第50版推荐单用SMX/TMP或联合亚胺培南治疗[3]。《国家抗微生物治疗指南》第3版推荐复方SMX/TMP联合头孢曲松钠,若多器官受累时可加用阿米卡星,免疫功能正常者疗程为3个月以上,免疫抑制者需两种药物联用,疗程为1年。
具体治疗方案:SMZ/TMP(75mg/15mg)/(kg·d)口服(p.o.),分2-4次+头孢曲松钠2g 静脉注射,每12小时给药1次(i.v. q.12h.),3-6周后,改为口服药物[4]。
即TMP-SMZ初始治疗可采用静脉滴注,剂量为一日15mg/kg(以甲氧苄啶计),分2-4次给药;联合头孢曲松(2g,静脉滴注,q12h)。病情稳定后TMP-SMZ改为口服,剂量调整为一日10mg/kg,分2-3次给药。
患者多为中老年人群,患多种基础疾病。临床表现缺乏特异性,病情进展后可能出现肺内空洞,甚至播散至中枢神经系统、皮肤等部位,引发相应临床症状。肺部检查可见斑片状浸润影、结节影、空洞影,部分病灶边界模糊,易被误诊为细菌性肺炎或肺结核、肺癌。
BALF送检后,经需氧培养(25-37℃,培养时间延长6 -14天),在血琼脂平板上形成特征性菌落。48小时不易见菌落,6天菌落呈针尖大小,白色圆形凸起干燥小菌落。按照行业规范培养48小时易漏检。镜检见革兰阳性分枝状菌丝,弱抗酸染色阳性(弱抗酸性是诺卡氏菌的特征之一),结合生化试验及分子生物学检测(16S rRNA基因测序),明确鉴定为脓肿诺卡氏菌[5]。
诺卡氏菌属主要经呼吸道侵入人体,引发肺部感染。亦可累及皮肤软组织与中枢神经系统。其中脓肿诺卡氏菌是诺卡氏菌属中具有重要临床意义的致病菌。脓肿诺卡氏菌生长特性特殊,常规培养易漏检,且极易造成人体播散性感染,可侵袭中枢神经系统。
该菌导致的肺部感染在临床需应引起足够重视,避免由于该菌漏检而致临床误诊误治,进而影响患者预后。因此,本研究结合临床病例,对该菌的生物学特性、感染特点及临床诊治要点进行探讨,旨在为临床识别和处理脓肿诺卡氏菌感染提供参考依据。
病原学特点,脓肿诺卡氏菌是一种革兰阳性需氧菌,广泛存在于土壤、水等自然环境中,属于条件致病菌,其弱抗酸性易与结核分枝杆菌混淆,鉴别要点在于诺卡氏菌抗酸染色脱色时用1%盐酸乙醇,脱色速度更快,且分枝状菌丝更明显。该菌产生水解酶,侵袭肺组织并形成脓肿,还可通过血行播散至全身。
诊断难点,临床表现与肺结核、普通细菌性肺炎重叠,早期易误诊。该菌在血琼脂平板与巧克力琼脂平板上生长缓慢,48小时培养易漏检。BALF培养周期长,需延长培养时间至6天以上。实验室鉴定难度大,镜下形态与其他放线菌、真菌相似,16S rRNA基因测序是目前鉴定的金标准。
治疗原则,脓肿诺卡氏菌对磺胺类药物高度敏感,首选SMZ-TMP,治疗疗程需足够长(肺内感染一般6-12个月,播散性感染需12个月以上),避免复发。对磺胺类药物过敏者,可选用头孢曲松、阿米卡星、亚胺培南等药物联合治疗。同时需积极处理基础疾病,增强患者免疫力。
实验室生物安全事项:操作时需注意生物安全防护,脓肿诺卡氏菌可通过气溶胶传播,操作人员应佩戴口罩、手套,在生物安全柜内进行接种、涂片等;培养阳性的标本及培养基需高压灭菌后再处理,防止实验室感染。
对于免疫功能低下患者,出现不明原因发热、咳嗽、肺部空洞影,且常规抗感染治疗无效时,需警惕诺卡氏菌感染的可能,及时送检BALF并延长培养时间。实验室诊断需结合形态学、培养特性、生化试验及分子生物学检测,避免与结核分枝杆菌相混淆。
治疗首选复方磺胺甲恶唑,足疗程用药是治愈的关键,同时重视基础疾病的管理和免疫功能的恢复。该患者用复方磺胺甲噁唑(SMX/TMP)联合头孢曲松抗感染治疗,炎症指标降低,呼吸道感染症状改善,并恢复正常,治疗有效。
实验室与临床密切配合,提高对脓肿诺卡氏菌感染的识别能力。脓肿诺卡氏菌按常规培养易漏检,导致临床误诊误治。脓肿诺卡氏菌感染导致脓肿诺卡氏菌肺炎或肺脓肿无特征性临床症状。微生物室应根据涂片涂片结果,延长培养时间。最终通过质谱技术快速准确鉴定。有条件的也可以通过PCR方法进行快速鉴定或者基因测序进行菌种鉴定。
为避免诺卡氏菌属漏检,可从标本前处理、培养分离、鉴定检测三个核心环节优化实验室检验流程。
标本前处理强化,对肺泡灌洗液、痰液等呼吸道标本,采用4%NaOH消化去黏液后,再行离心浓缩(3000r/min,15min),取沉淀接种,提升菌量检出率,避免菌团未分散导致的漏检。
培养分离条件优化,培养基选择:同时接种血琼脂平板、巧克力琼脂平板及沙保弱培养基,沙保弱培养基可抑制真菌外的杂菌,辅助纯化。
培养环境与时长:需设置需氧环境(5%-10%CO₂环境更佳),培养时长延长至7-14天,每日观察菌落形态,避免因“早期无菌落”误判为阴性;切勿过早丢弃平板,诺卡菌生长缓慢,易被快速生长的细菌掩盖。
鉴定检测流程完善,建立复检机制:对初筛阴性但临床高度怀疑诺卡氏菌属感染的标本,需重新取样并采用“双培养基+延长培养” 复检,避免单次检测的假阴性。
同时,加强实验室人员与质控管理。对实验室人员培训,掌握诺卡氏菌菌落形态、染色特性及生长规律,避免与快速生长分枝杆菌、棒状杆菌等混淆。不定期开展室内质控,采用已知诺卡氏菌标准菌株(ATCC 19247)进行模拟标本检测,验证流程的有效性。

同济大学附属同济医院副主任技师,同济大学副教授,博士生导师
参考文献
[1]陈茶,屈平华,实用医学细菌分类与临床应用手册[M].北京:科学出版社,2022:524.
[2]中华人民共和国国家卫生和计划生育委员会.WS/T 499—2017 《下呼吸道感染细菌培养操作指南》[S].北京:中国标准出版社, 2017:7.
[3]桑福德(Jay p.Sanford).《热病:桑福德抗微生物治疗指南》(The Sanford Guide to Antimicrobial Therapy)[M].范洪伟译.第50版. 北京:中国协和医科大学出版社,2021:11.
[4]何礼贤,肖永红,陆权等.国家卫生健康委合理用药专家委员会.《国家抗微生物治疗指南》[M].第3版.北京:人民卫生出版社,2023:137.
[5]Brown-Elliott BA,Brown JM,Conville PS,et al.Clinical and laboratory features of the Nocardia spp.based on current molecular taxonomy[J]. Clin Microbiol Rev,2006,19(2):259-282.



